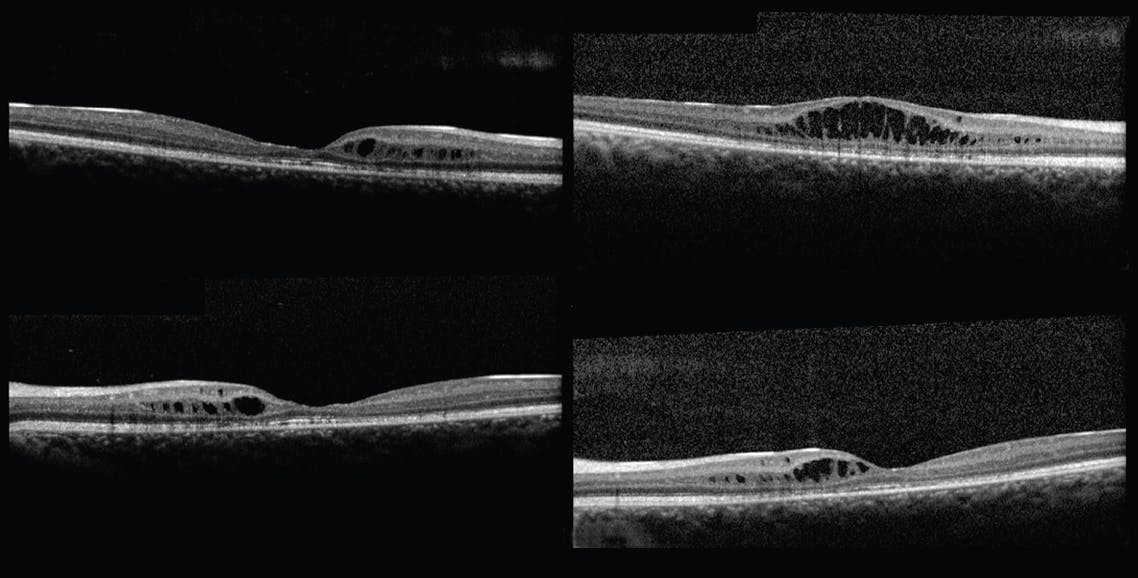

CASE PRESENTATION
An 18-year-old White male was referred for progressive bilateral vision loss. He had no significant ocular or family history, and his general health was unremarkable. On initial examination, his BCVA was 20/50 OU. The anterior segment was normal, but the bilateral fundus examination revealed a lack of macular reflex with a spoke-wheel pattern and no peripheral changes. Fundus photography exhibited a gold leaf-like reflex in the posterior pole extending beyond the vascular arcade in each eye, characteristic of Mizuo-Nakamura phenomenon (Figure 1).
OCT showed foveal retinoschisis between the inner nuclear layer and outer plexiform layer, which was confined to the perifoveal space (Main Figure 2). His peripheral visual field was normal. A negative electroretinography result confirmed the diagnosis of juvenile X-linked retinoschisis (XLRS), and genetic testing revealed the XLRS1 pathogenic variant. The patient’s brother was examined without any evidence of XLRS.
The Mizuo-Nakamura phenomenon did not appear at the 1-year follow-up. At this time, OCT revealed the progression of retinoschisis, spreading to a wider area and to the right fovea (Figure 3), accompanied by worsening BCVA (20/70 OD). He has been followed annually and demonstrates stable BCVA (20/70 OD and 20/50 OS) and retinal findings.
DISCUSSION
XLRS is an early-onset retinal degeneration, characterized by splitting within the inner retinal layers. Clinical hallmarks of this disease include reduced visual acuity, a spoke-wheel pattern in the macula with cystic changes on OCT, and, in some cases, peripheral schisis.1,2
There is great variation in XLRS disease severity, even among individuals with the causative XLRS1 mutation.3 The OCT appearance of a schitic cavity may fluctuate in density and morphology, even in young patients, which may help explain the heterogeneity of results in XLRS treatment trials.
Over time, the schitic cavities tend to collapse, leading to secondary atrophic changes, including at the level of the retinal pigment epithelium. This is often associated with profound vision loss in middle-to-late age.4
Mizuo-Nakamura phenomenon is described as reversible changes in the fundus color from a gold leaf-like reflex under light conditions to the normal orange-red color after full dark adaptation. Typically seen in Oguchi disease, a form of congenital night blindness, it has also been described in X-linked recessive cone dystrophy, Stargardt disease, and XLRS.5-8
The exact pathophysiology of the Mizuo-Nakamura phenomenon is unknown, but it may be caused by an excess of extracellular potassium in the retina owing to decreased scavenging capacity of the Müller cells.8 In XLRS, Müller cell dysfunction occurs secondary to the splitting of the retinal layers.
THE HYPOTHESIS
The patient in this case was molecularly proven to have only XLRS, without the causative genetic abnormalities for Oguchi disease. These findings, together with observations and data from the literature,9 led us to hypothesize that XLRS alone can be responsible for the Mizuo-Nakamura phenomenon. However, the real underlying mechanism for this reflex has not been clearly determined.
1. Molday LL, Hicks D, Sauer CG, Weber BH, Molday RS. Expression of X-linked retinoschisis protein RS1 in photoreceptor and bipolar cells. Invest Ophthalmol Vis Sci. 2001;42(3):816-825.
2. Vincent A, Shetty R, Yadav NK, Shetty BK. Foveal schisis with Mizuo phenomenon: etiopathogenesis of tapetal reflex in X-linked retinoschisis. Eye (Lond). 2009;23(5):1240-1241.
3. Pimenides D, George ND, Yates JR, et al. X-linked retinoschisis: clinical phenotype and RS1 genotype in 86 UK patients. J Med Genet. 2005;42(6):e35.
4. Campbell TG, Elder J, Ruddle J. Spontaneous resolution of schitic cavities in XLRS. Ophthalmic Genet. 2021;42(6):765-767.
5. Oguchi C. Ueber eine Abart von Hemeralopie. Acta Soc Ophthalmol Jpn. 1907;11:123-134.
6. Heckenlively JR, Weleber RG. X-linked recessive cone dystrophy with tapetal-like scheen, a new recognized entity with Mizuo-Nakamura phenomenon. Arch Ophthalmol. 1986;104(9):1322-1328.
7. Nobel KG, Margolis S, Carr RE. The golden tapetal sheen reflex in retinal disease. Am J Ophthalmol. 1989;107(3):211-217.
8. Dejong PTVM, Zrenner E, van Meel GJ, Keuren JEE, von Norren D. Mizuo phenomenon in X-linked retinoschisis. Pathogenesis of the Mizuo phenomenon. Arch Ophthalmol. 1991;109(8):1104-1108.
9. Wakabayashi K, Sakai-Wakabayashi Y, Ishigami C. Mizuo-Nakamura phenomenon in X-linked retinoschisis. Am J Ophthalmol Case Rep. 2022;10(26):101529.